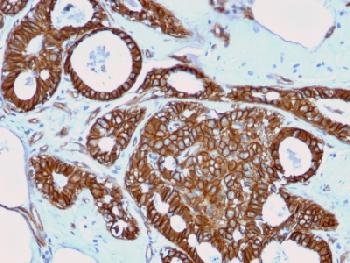

Anti-Catenin, beta (CTNNB1) Recombinant Mouse Monoclonal Antibody (Clone:rCTNNB1/2173)
Figure 1: Formalin-fixed, paraffin-embedded human Breast Cancer stained with Beta-Catenin Mouse Recombinant Monoclonal Antibody (rCTNNB1/2173).
Roll over image to zoom in
Shipping Info:
For estimated delivery dates, please contact us at [email protected]
| Format : | Purified |
| Amount : | 100 µg |
| Isotype : | Mouse IgG1, kappa |
| Purification : | Protein A/G |
| Content : | 200µg/ml of recombinant MAb purified by Protein A/G. Prepared in 10mM PBS with 0.05% BSA & 0.05% azide. Also available WITHOUT BSA & azide at 1.0mg/ml. |
| Storage condition : | Antibody with azide - store at 2 to 8°C. Antibody without azide - store at -20 to -80°C. Antibody is stable for 24 months. Non-hazardous. |
Immunofluorescence (1-2µg/ml); Western Blot (1-2µg/ml); ,Immunohistochemistry (Formalin-fixed) (1-2µg/ml for 30 minutes at RT),(Staining of formalin-fixed tissues requires heating tissue sections in 10mM Tris with 1mM EDTA, pH 9.0, for 45 min at 95°C followed by cooling at RT for 20 minutes),
For Research Use Only. Not for use in diagnostic/therapeutics procedures.
| Subcellular location: | Cytoplasm, Nucleus, Cytoplasm, Cell junction, Cell junction, Cell membrane, Cytoplasm, Cytoplasm, Cell junction, Cytoplasm |
| Post transnational modification: | Deacetylated at Lys-49 by SIRT1. |
| Tissue Specificity: | Expressed in several hair follicle cell types: basal and peripheral matrix cells, and cells of the outer and inner root sheaths. Expressed in colon. Present in cortical neurons (at protein level). Expressed in breast cancer tissues (at protein level) (PubMed:29367600). |
| BioGrid: | 107880. 630 interactions. |
|
There are currently no product reviews
|

.png)













